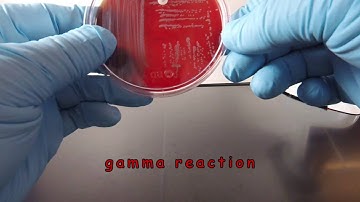
Staphylococcus saprophyticus on Blood Agar with a NB Disc
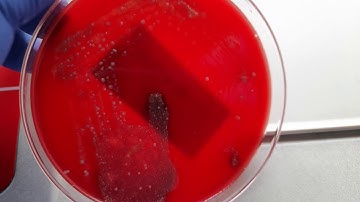
Throat swab on blood agar showing Steptoccus pyogens pin point beta hemolytic colony
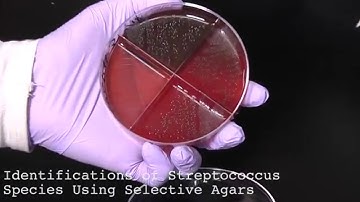
9. How to Identify Streptococcus Species Using Selective Agars
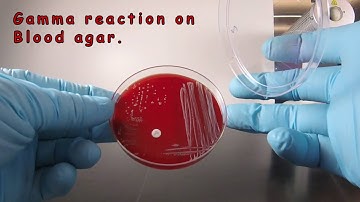
Staphylococcus epidermidis on Blood Agar with a NB Disc

⬇ DOWNLOAD NOW
Kalau muncul iklan pop-up, tutup lalu klik tombol kembali
Download lagu Streptococcus pyogenes on Blood Agar with a Taxo A Disc secara gratis hanya untuk keperluan promosi. Dukung artis favorit kamu dengan membeli musik original di iTunes atau platform resmi lainnya.
 Inoculating a Blood Agar Plate and adding a Taxo A Bacitracin Disc
Inoculating a Blood Agar Plate and adding a Taxo A Bacitracin Disc
 Streptococcus pyogenes is inoculated to a blood agar plate with a Taxo A disc. You should expect to…
Streptococcus pyogenes is inoculated to a blood agar plate with a Taxo A disc. You should expect to…
Staphylococcus saprophyticus on Blood Agar with a NB Disc
Staphylococcus saprophyticus on Blood Agar with a NB Disc
Throat swab on blood agar showing Steptoccus pyogens pin point beta hemolytic colony
Throat swab on blood agar showing Steptoccus pyogens pin point beta hemolytic colony
9. How to Identify Streptococcus Species Using Selective Agars
9. How to Identify Streptococcus Species Using Selective Agars
Staphylococcus epidermidis on Blood Agar with a NB Disc
Staphylococcus epidermidis on Blood Agar with a NB Disc
 Bacitracin test for Streptococcus pyogenes
Bacitracin test for Streptococcus pyogenes
 Beta-haemolytic colonies of Staphylococcus aureus and Streptococci on Blood agar demonstration
Beta-haemolytic colonies of Staphylococcus aureus and Streptococci on Blood agar demonstration